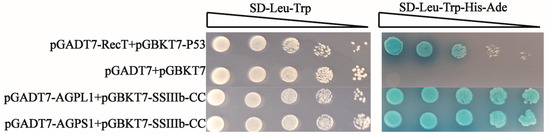

Abstract
Starch synthase collaboratively accomplishes the synthesis of starch by forming a protein complex. In barley (Hordeum vulgare L.), the interaction mechanisms within the soluble starch synthase 3 (SSIII) protein complex and their specific roles in starch biosynthesis remain poorly understood. To investigate proteins interacting with SSIII isoforms (SSIIIa/SSIIIb), the polyclonal antibodies against HvSSIIIa and HvSSIIIb were generated in rabbits. Co-immunoprecipitation (Co-IP) was employed to enrich HvSSIIIa- and HvSSIIIb-associated protein complexes from developing barley seeds. The potential interacting proteins were identified using mass spectrometry coupled with database searches. The results demonstrated the successful production of highly specific polyclonal antibodies against HvSSIIIa and HvSSIIIb. These antibodies were used to analyze the expression levels of HvSSIIIa and HvSSIIIb across different barley tissue and seed developmental stages. Both isoforms exhibited peak expression during early seed development. Further screening revealed several candidate interacting proteins, and the interacting proteins had some overlaps. Among them, adenosine diphosphate glucose pyrophosphorylase, as a key rate-limiting enzyme in starch synthesis, interacts with SSIII to jointly regulate the supply of ADP-glucose precursors. Differential proteins show functional differentiation. In SSIIIa, the interacting protein DELLA protein SLR1-like is involved in processes such as hormone regulation, and in SSIIIb, the interacting protein 14-3-3 is related to metabolism. These findings provide new insights into the composition and function of the SSIII protein complex in barley, facilitating future studies on its regulatory role in starch biosynthesis.
1. Introduction
Barley (Hordeum vulgare L.) is the fourth most cultivated cereal globally and is classified into hulled barley and naked barley (qingke), based on grain threshing characteristics [1,2]. Due to its nutritional benefits, such as glycemic control, and its adaptability to high-altitude deserts and extreme climate conditions, barley serves as a vital staple in harsh environments which are unsuitable for wheat and other cereals [3].
Starch synthases are on two major classes, based on their subcellular localization and association with starch granules: granule-bound starch synthase (GBSS) and soluble starch synthase (SS) [4,5]. While GBSS is primarily responsible for amylose synthesis, SS enzymes serve as the core catalytic components in amylopectin biosynthesis, facilitating both the elongation of glucan chains and the establishment of the branched architecture, characteristic of amylopectin [6,7]. The intricate process of amylopectin synthesis requires the coordinated action of SS with two additional enzymatic activities: starch branching enzymes (SBEs), which introduce α-1,6-glycosidic branch points, and starch debranching enzymes (SDBEs), which refine the branching pattern by removing misplaced branches [8,9,10]. Higher plants possess four distinct classes of soluble starch synthases (SSI, SSII, SSIII, and SSIV), which exhibit both overlapping and specialized functions in starch biosynthesis [11]. Among these, SSIII represents the largest isoform in terms of molecular weight, and is particularly important in determining amylopectin structure. Biochemical studies have demonstrated that SSIII preferentially elongates longer glucan chains (DP ≥ 30) during starch synthesis [12,13,14]. Genetic evidence further supports this functional specialization, as mutations disrupting SSIIIa activity result in compensatory increases in SSI-mediated synthesis of short-chain amylopectin (DP 6–12) [15,16].
The biosynthesis of starch depends on the synergistic action of multiple enzymes, where multiple enzymes organize into functional complexes to enhance catalytic efficiency and substrate specificity [17]. In maize (Zea mays) endosperm, SSIII forms a stable complex with several other starch biosynthetic enzymes, including ADP-glucose pyrophosphorylase (AGPase, the first committed step in starch synthesis), SSIIa, and SBEII isoforms. This multi-enzyme complex physically links substrate production (AGPase) with chain elongation (SSIIa/SSIII) and branching (SBEIIa/b) activities, thereby optimizing the flux through the amylopectin biosynthetic pathway [18,19]. Recent research has revealed additional layers of regulation in these enzymatic complexes. A study by Wan Jianmin’s group identified the OsLESV-FLO6 protein complex in rice (Oryza sativa) that serves as a scaffold to recruit SSIII and isoamylase 1 (ISA1) to starch granules, thereby spatially organizing the enzymes involved in amylopectin chain elongation and debranching [20]. Similarly, in maize endosperm, a high-molecular-weight complex (>669 kDa) containing SSIII, SSIIa, SBEIIa and SBEIIb has been characterized, with SSIII serving as both a structural and regulatory component that influences total starch accumulation rates [21,22]. The formation of SSIII-containing multi-enzyme complexes appears to be an evolutionarily conserved feature of starch biosynthesis across cereal species [23]. Advanced protein separation techniques, including gel permeation chromatography and co-immunoprecipitation, have identified two distinct complexes in rice endosperm: (1) a large (>700 kDa) complex containing SSIIa, SSIIIa, SSIVb, SBEI, SBEIIb and pullulanase (PUL), and (2) a smaller (200–400 kDa) complex comprising SSI, SSIIa, SBEIIb, ISA1, PUL and plastidial starch phosphorylase 1 (PHO1) [24,25,26]. These findings suggest a sophisticated partitioning of enzymatic activities between different complexes that may allow for fine-tuning of amylopectin structure under varying physiological conditions. The emerging picture from these studies reveals that starch synthases, particularly SSIII isoforms, could be important in determining both the quantity and quality of starch in major cereal crops, including barley. The formation of dynamic protein complexes might allow for precise coordination between substrate supply, chain elongation and branching activities. A deeper understanding of the functions and regulatory mechanisms of these two enzymes is significant for improving the quality and yield of crop starch. The current study provides important foundational knowledge for understanding how the barley SSIII isoforms (HvSSIIIa and HvSSIIIb) participate in these regulatory networks to control amylopectin synthesis.
2. Materials and Methods
2.1. Bioinformatics Analysis of HvSSIIIa, HvSSIIIb
Multiple sequence alignment of HvSSIIIa and HvSSIIIb homologs was conducted using ClustalX 2.0 with default parameters. The ClustalX comparison file was placed in MEGA 5.1 for phylogenetic tree visualization. GSDS2.0 (https://gsds.gao-lab.org/Gsds_help.php, accessed on 22 September 2022) was used for structural visualization of HvSSIIIa, HvSSIIIb homolog genes. MEME5.5.8 (https://meme-suite.org/meme/tools/meme, accessed on 4 October 2022) was used to predict protein conserved domain, with 10 motifs set for search, and the results were visualized using TBtools4.4.5. Interpro89.0 (https://www.ebi.ac.uk/interpro, accessed on 17 October 2022) was used to predict protein conservation domains, and the results were visualized using IBS. 2.0 (https://ibs.renlab.org/, accessed on 26 October 2022) (September 2022–November 2022).
2.2. Construction of pGEX-6p-1-HvSSIIIa-N and pET-30a-HvSSIIIb-N Expression Vectors
RNA was extracted from “Tongmen Xika Bai”, as the material and reverse transcribed into cDNA as the template. Primers F: 5′-ATGGAGATGGCTCTCCGGCCA-3′ and R: 5′-TCAGAATTTTCGAGCGGCATGATA-3′ were designed using the designed HvSSIIIa gene sequence. The HvSSIIIb gene sequence was designed with primers F: 5′-ATGGAGATGGCTCTCCGGGCGCAG-3′ and R: 5′-TCAGTTCTTGCGCGCGGAATGGTA-3′ for PCR reaction (the annealing temperature in the PCR reaction is 69 °C). The purified DNA fragments were purified using the gel extraction kit (Cwbio, Nanjing, China), ligated into the pMD19-T vector (Takara Bio Inc., Beijing, China), and transferred into E. coli DH5α for colony PCR screening of monoclones. The positive clonal plasmids were selected and sent to Chengdu Qingke Biotechnology Co., Ltd. (Chengdu, China) for sequencing. The translated amino acid sequences were compared with the GenBank NCBI 266.0 (BLAST: Basic Local Alignment Search Tool) database using BLAST (December 2022–January 2023).
HvSSIIIa, using vector linear primer F: 5′-ttccaggggcccctgggatccATGGAGATGGCTCTCCGGC-3′ and R: 5′-ctcgagtcgacccgggaattcTCAGAATTTTCGAGCGGCA-3′, HvSSIIIb, using vector linear primer F: 5′-ttgtcgacggagctcgaattcATGGAGATGGCTCTCCGGG-3′ and R: 5′-gccatggctgatatcggatccTCAGTTCTTGCGCGCGGA-3′ for PCR reaction (the annealing temperature in the PCR reaction is 69 °C); the digestion sites of BamHI and EcoRI were added. The amplified fragments were attached to the expression vector, and the positive transformed colonies were screened by the PCR method. The positive clone recombinant plasmids were sent to Chengdu Qing Ke Biotechnology Co., Ltd. (Chengdu, China) for sequencing verification. The results indicated that the expression vectors of pGEX-6p-1-HvSSIIIa-N and pET-30a-HvSSIIIb-N were successfully constructed. Recombinant plasmids were isolated from the conjugations using the Fast Pure Plasmid Mini Kit (Vazyme, Nanjing, China). The expression plasmid vectors were transferred into E. coli BL21 (DE3) Rosetta, and the recombinant HvSSIIIa and HvSSIIIb fusion proteins were prepared using the selected transformation vectors (February 2023–April 2023).
2.3. Real-Time Fluorescence Quantitative PCR
RNA was extracted from the roots, stems, leaves and grains at different stages of barley “Tongmen Xika Bai”, using the total RNA extraction kit (Cwbio, Nanjing, China). Reverse transcription reactions were carried out using reverse transcription kits (Cwbio, Nanjing, China). Specific primers were designed on Primer 5.0 software. HvSSIIIa gene sequence design primer F: 5′-GTTCCACCGGATGCCTAT-3′, R: 5′-FRCCGAGACCTCCAACCTTT-3′. The HvSSIIIb gene sequence was designed with primers F: 5′-ATTCTGCCCTGGAGTTTC-3′ and R: 5′-GCTTTGCCGATGTGATGT-3′ for qPCR reaction. The experimental reaction system was 10 μL: TB Green Premix Ex Taq™ II (2×) 5 μL (Tli TaKaRa, Beijing, China), upstream primers 0.5 μL, downstream primers 0.5 μL, cDNA template (diluted 10 times) 1 μL RNase-free H2O 3μL. Reaction was carried out using the CFX96 Touch Real-Time PCR Detection System (Bio-Rad, Hercules, CA, USA). The reaction parameters were as follows: ① Pre-denaturation: 95 °C for 2 min; ② PCR cycles 40 times: 95 °C for 15 s, 60 °C for 20 s; and ③ Melting curve analysis: 95 °C for 15 s, 60 °C for 1 min, 95 °C for 15 s. Three technical replicates were set for each sample, and an internal reference gene β-actin control was also set. After the reaction was completed, the Ct values were derived. Outliers (repetitions with a standard deviation greater than 0.5) were eliminated, and the average value was taken as the Ct value of the sample. The relative expression level of the target gene was calculated by the 22−ΔΔCt method, using stably expressed internal reference genes (February 2023–March 2023).
2.4. Preparation and Purification of Recombinant HvSSIIIa, HvSSIIIb Fusion Protein
E. coli Rosetta carrying the pGEX-6p-1-HvSSIIIa-N recombinant plasmid was cultured in 0.1 L LB (Luria–Bertani) medium containing 50 µg/mL ampicillin. The E. coli Rosetta transformants carrying the pET-30a-HvSSIIIb-N recombinant plasmid were cultured in a medium containing 50 µg/mL kanamycin (Kan). Cultures were incubated at 37 °C for 8 h in an orbital shaker (150 rpm). After adding 0.5 mM IPTG, induction was performed at 28 °C for 6 h (150 rpm). Samples were taken every 2 h, and bacterial cells were collected at 4200 rpm for 10 min at 4 °C. The cells were resuspended in PBS (137 mM NaCl, 10 mM Na2HPO4, 2.7 mM KCl, 1.8 mM KH2PO4, pH 7.4) and ultrasonically extracted to isolate the recombinant protein. The supernatant was centrifuged at 12,000 rpm for 5 min at 4 °C to separate the soluble protein. The total extract, soluble fraction, and insoluble fraction were separated by sodium dodecyl sulfate-polyacrylamide gel electrophoresis (SDS-PAGE), followed by Coomassie Brilliant Blue (CBB) staining, for observation.
The E. coli Rosetta transformation was cultured overnight at 28 °C in 0.1 L of LB medium containing 50 µg/mL ampicillin/carbenicillin and 50 µg/mL IPTG. This resulted in the recombinant pGEX-6p-1-HvSSIIIa-N and pET-30a-HvSSIIIb-N fusion proteins. The recombinant fusion proteins were purified using the Biocytin HIS-tag/GST-tag protein purification kit, and the ultrasonic parameter power was 200 W. The intermittent ultrasonic method was adopted, with 5 s of ultrasonic treatment followed by 5 s of pause, for a total of 10 min. The eluted proteins were separated by SDS-PAGE for further purification. The target protein bands were recovered from the gel through electrophoresis (May 2023–July 2023).
For antibody production, 500 µg of purified recombinant proteins (pGEX-6p-1-HvSSIIIa-N and pET-30a-HvSSIIIb-N) were emulsified with 500 µL of complete Freund’s adjuvant (1:1 v/v), and administered subcutaneously to New Zealand white rabbits (2 kg body weight). Procedures were approved by the Animal Care and Use Committee of Sichuan Agricultural University (no DKY-S20230605, Chengdu, China). The rabbits used in the experiment were housed in the Breeding Room located on the 7th Floor of Building 3, College of Agronomy, Sichuan Agricultural University, Chengdu, China, under a separate cage-rearing mode. The indoor environment was strictly controlled, with temperature maintained at 18–22 °C. Daily management included cleaning up excrement in the cages, replacing contaminated bedding, and providing fresh water and rabbit food for the rabbits. For the immunization procedure, primary subcutaneous immunization was performed first, followed by five booster subcutaneous injections at 2-week intervals. Each injection contained 500 µg of antigen emulsified with 500 µL of incomplete Freund’s adjuvant, at a volume ratio of 1:19. During the subcutaneous immunization and subsequent subcutaneous injections, the area with thicker subcutaneous fat on the rabbit’s back was selected as the injection site, and the drug solution was injected slowly. After each injection, close attention was paid to checking for bleeding or swelling at the puncture site, as well as monitoring whether the rabbits could move normally and eat and drink, to ensure their health status. Three days post-final immunization, blood was collected carefully, to maintain stability (without shaking), and allowed to clot overnight at room temperature, in darkness. Serum was separated by centrifugation (3000× g, 10 min, 4 °C) and mixed with glycerol (1:1 v/v) for cryopreservation at −80 °C. Antibody titers were determined by immunoblotting against the recombinant antigens (August 2023–October 2023).
2.5. Western Blot Detects the Sensitivity and Specificity of Anti-Recombinant Protein Polyclonal Serum
To analyze protein expression, total protein was extracted from developing grains of barley (Hordeum vulgare L. cv. ’Tongmen Xika Bai’). Protein samples (25 μg) were mixed with 5× SDS-PAGE loading buffer at a 1:4 ratio and denatured by boiling at 95 °C for 5 min. The denatured proteins were separated by 10% SDS-PAGE electrophoresis at 100 V constant voltage, followed by Coomassie Brilliant Blue staining for 2 h and destaining for 1 h, to verify equal loading. Protein concentration was quantified using the Bradford protein assay (Beyotime Biotechnology, Shanghai, China). For immunoblotting, proteins were transferred to a polyvinylidene fluoride (PVDF) membrane at 100 V, for 90 min. The membrane was blocked with 5% (w/v) skim milk in Tris-buffered saline (TBS; 20 mM Tris-HCl, 137 mM NaCl, pH 7.4) for 1 h, at room temperature. Primary antibody incubation was performed overnight at 4 °C, using polyclonal antisera against HvSSIIIa or HvSSIIIb diluted 1:400 in blocking buffer. After three washes with TBST (TBS containing 0.5% Tween-20), the membrane was incubated with horseradish peroxidase (HRP)-conjugated goat anti-rabbit IgG secondary antibody (Beyotime; 1:10,000 dilution) for 1 h, at room temperature. Following three additional TBST washes, protein bands were visualized using an enhanced chemiluminescence (ECL) detection kit (Beyotime). To verify antibody specificity, identical procedures were performed using protein extracts from Escherichia coli expressing recombinant HvSSIIIa or HvSSIIIb. This comprehensive approach ensured specific detection of target proteins while confirming the absence of cross-reactivity with other barley proteins (November 2023–December 2023).
2.6. Co-Immunoprecipitation (Co-IP) and Mass Spectrometry Analysis
Barley seeds (0.1 g) were collected 25 days after pollination, and ground in liquid nitrogen; 1 mL of cell lysis buffer was added, to extract total protein. The extracted total protein was divided into two parts; one part was used as input, and the remaining sample was subjected to immunoprecipitation using Protein A+G Agarose (Beyotime, Shanghai, China). The loading volume of the input was 5% of the total protein. Both the experimental group and the control group were subjected to SDS-PAGE and Western blot analysis. Co-IP agarose beads were sent to Shenzhen Micro Nano Biotechnology Co., Ltd. (Shenzhen, China) for proteomics analysis, based on nano-liquid chromatography–tandem mass spectrometry (nano-LC-MS/MS). The criterion was that the candidate proteins should be specifically present in the IP group and have an abundance more than 1.5 times that of the IgG group. Based on the existing literature on starch synthesis, we screened the interacting proteins (January 2024–March 2024).
2.7. Validation of Interacting Proteins
Based on the published HvSSIIIa and HvSSIIIb gene sequences (NCBI accession numbers: HvSSIIIa: XP_044965135.1, HvSSIIIb: XP_044967973.1), specific primers for yeast two-hybrid experiments were designed using Novogene’s online primer design tool (Table S1). PCR amplification was performed using bacterial cultures of positive clones as DNA templates, with all primers synthesized by Chengdu Barley Biotechnology Co., Ltd. (Chengdu, China). The amplified products were purified and subsequently recombined using the Aibotek 2× MultiF Seamless Assembly Mix (Aidlab Biotechnologies, Beijing, China) through a 10 min incubation at 50 °C, followed by immediate cooling at 4 °C. The recombinant products were then transformed into competent E. coli DH5α cells for positive clone selection, followed by plasmid extraction using standard alkaline lysis methods.
For yeast transformation, a single colony of Saccharomyces cerevisiae strain AH109 was inoculated from a YPDA (Yeast Extract Peptone Dextrose Adenine) plate into 20 mL of liquid YPDA medium and grown overnight at 28 °C, with 200 rpm shaking. Five milliliters of this culture was then transferred to 50 mL fresh YPDA medium in a 100 mL Erlenmeyer flask and incubated under the same conditions until reaching mid-log phase (OD600 ≈ 0.5). The cells were harvested by centrifugation at 10,000× g for 2 min at room temperature, washed twice with 0.1 M lithium acetate (LiAc), and finally resuspended in an appropriate volume of 0.1 M LiAc, to prepare competent cells. The transformation mixture was prepared in sterile 1.5 mL microcentrifuge tubes containing 600 μL of 50% PEG3350 (w/v), 110 μL of 1× LiAc (0.1 M), 2 μg of each plasmid DNA (pGBKT7 and pGADT7 constructs), and 10 μL of denatured salmon sperm DNA (10 mg/mL) as carrier DNA.
The recombinant plasmids (pGBKT7 and pGADT7 derivatives) were co-transformed into the freshly prepared yeast competent cells using the lithium acetate/polyethylene glycol method. The coiled-coil domains (CC) of both starch synthases were cloned into pGBKT7 (bait vectors: pGBKT7-HvSSIIIa-CC [400–800 aa] and pGBKT7-HvSSIIIb-CC [800–1200 aa]), while AGPase subunits were inserted into pGADT7 (pGADT7-HvAGPL1 and pGADT7-HvAGPS1). Following transformation, cells were plated on appropriate selection media (-Leu/-Trp) and incubated at 28 °C for 3–5 days. Protein–protein interactions were assessed by growth on quadruple-dropout media (-Ade/-His/-Leu/-Trp) and through α-galactosidase activity assays, using X-α-Gal (5-bromo-4-chloro-3-indolyl-α-D-galactopyranoside) as substrate. The development of blue coloration within 8–24 h indicated positive protein interactions, while white colonies served as negative controls (May 2024–July 2024).
2.8. GST Pull-Down Assay for Protein Interaction Validations
The purified 1 mg GST-tagged fusion protein (including GST-tagged protein, GST-HVAGPL1, and GST-CC-HVSSIIIA) was incubated in a rotating solution at 10 μL GST Agarose Beads, at 4 °C, for 4 h, followed by overnight incubation with the supernatant from seed lysis. The mixture was then subjected to 800 r/min 4 °C centrifugation for 2 min, with the supernatant discarded. It was washed with 200 μL of PBS and centrifuged again for 2 min, with the supernatant removed, and this process was repeated five times. After washing, 40 μL PBS of Agarose Beads was added to resuspend the protein, followed by the addition of 10 μL of 5×Protein Loading buffer. The mixture was boiled for 1 min, and the protein was then subjected to SDS-PAGE electrophoresis. After electrophoresis, the interacting proteins were detected by Western blot: after membrane transfer, the PVDF membrane was sealed with 10% skimmed milk powder for 2 h, and then the primary antibody (HIS-HvAGPL1, diluted at 1:500) was added and incubated overnight at 4 °C. After washing TBST three times, we added HRP-labeled secondary antibody (goat anti-rabbit IgG) and incubated at room temperature for 2 h (diluted at 1:20,000); after re-washing, the signal was detected by developing with the ECL chemiluminescence kit (August 2024–November 2024).
3. Results
3.1. Structural and Phylogenetic Analysis of HvSSIIIa and HvSSIIIb Proteins
The conserved motifs of HvSSIIIa and HvSSIIIb proteins were analyzed using MEME software (with parameters set to identify up to 10 conserved motifs). The average consistency of pairwise alignment of the eight sequences in the C-terminal region was 85.3%, and the minimum consistency was 80.50%, with particularly high sequence similarity in their C-terminal regions (Figure 1A,B). Both proteins contain characteristic domains of the glycosyltransferase family, including tandem GT-5 and GT-1 catalytic domains that utilize ADP-glucose as a substrate donor for α-1,4-glycosidic bond formation during glucan chain elongation. Notably, we identified conserved coiled-coil domains in both isoforms, suggesting potential roles in protein–protein interactions (Figure 1C).

Figure 1.
Comparative analysis of HvSSIIIa and HvSSIIIb protein sequences across major cereal crops. (A) Conserved motif architecture of HvSSIIIa and HvSSIIIb identified through MEME analysis, showing the relative positions and conservation of 10 characteristic motifs shared between the two isoforms. The numbered boxes (1–10) represent distinct conserved sequence elements. (B) Sequence logo representation of the 10 conserved motifs, demonstrating amino acid conservation at each position. Residue height reflects conservation level, with the most invariant positions showing maximal letter height. Color coding indicates amino acid properties: polar (green), nonpolar (black), acidic (red), and basic (blue). (C) Domain organization predicted by InterProScan, highlighting; glycosyltransferase domains (GT-1 and GT-5, orange boxes), coiled-coil regions (CC, purple ovals), species-specific insertions (gray bars), and N-terminal transit peptides (green stripes). (D) Phylogenetic relationships of starch synthase III proteins from major cereal species: Hordeum vulgare: HvSSIIIa (this study), HvSSIIIb (this study), Triticum aestivum: TaSSIII (XP_044448522.1), TaSSIII-1 (XP_044334384.1), Zea mays: ZmSSIII (NP_001104881.2), ZmSSIIIb-2 (NP_001106015.2), Oryza sativa: OsSSIIIa (XP_015650668.1), OsSSIII (XP_015636215.1), and control proteins: HvPTST1 (XP_044952290.1, barley plastidial targeting protein), and HvLESV (XP_044981401.1, barley leaf starch accumulation regulator). The maximum-likelihood tree was constructed using MEGA11 with 1000 bootstrap replicates (values shown at nodes). Scale bar indicates amino acid substitutions per site. The Neighbor-Joining algorithm is used in MEGA. The dashed box highlights the close evolutionary relationship between barley and wheat SSIII isoforms.
Phylogenetic reconstruction of starch synthase sequences from major cereal crops demonstrated that HvSSIIIa and HvSSIIIb form a distinct clade with wheat orthologs, sharing >90% amino acid identity (Figure 1D). In contrast, these barley isoforms showed greater evolutionary divergence from starch synthases in maize, rice, and tobacco, with amino acid identities ranging from 65 to 78%. This phylogenetic pattern reflects the closer evolutionary relationship between barley and wheat within the Triticeae family, while highlighting significant sequence divergence among starch synthases from more distantly related crops.
3.2. Expression and Purification of HvSSIIIa and HvSSIIIb Proteins
The PCR amplification produced individual specific bands for SSIIIa and SSIIIb, with approximately of 4782 bp, and 3831 bp, respectively, and sequencing confirmed the successful amplification of the target genes (Figure 2A). Due to challenges in expressing these full-length proteins in microbial systems, we generated N-terminal fragments for antigen production: HvSSIIIa (1–252 aa) and HvSSIIIb (41–366 aa), yielding pGEX-6p-1-HvSSIIIa-N and pET-30a-HvSSIIIb-N constructs (Figure 2B). Sequence verification confirmed correct insertion and reading frame maintenance in the recombinant plasmids (Figure 2C,F).

Figure 2.
Construction, expression, and purification of recombinant HvSSIIIa and HvSSIIIb proteins. (A) Full-length gene amplification: Lane 1, HvSSIIIa (4782 bp); Lane 2, HvSSIIIb (3831 bp); M, DL5000 DNA marker. (B) Recombinant plasmid verification: Lane 3, pGEX-6p-1-HvSSIIIa-N (5737 bp); Lane 4, HvSSIIIa-N insert (756 bp); Lane 5, pET-30a-HvSSIIIb-N (6403 bp); Lane 6, HvSSIIIb-N insert (978 bp); M, DL5000 DNA marker. (C) pGEX-6p-1-HvSSIIIa-N vector map, showing GST-tag (N-terminal), HvSSIIIa-N insert (1–252 aa), multiple cloning site, and ampicillin resistance marker. (D) Time-course induction of GST-HvSSIIIa-N: Lanes 0–6, IPTG induction duration (hours); black arrow indicates GST-HvSSIIIa-N (~55 kDa); M, 10–180 kDa protein marker; CL, total cell lysate. (E) GST-HvSSIIIa-N purification profile: FT, flow-through; W1–W3, washes with non-denaturing lysis buffer; E1–E3, elutions with reduced glutathione; black arrow indicates purified GST-HvSSIIIa-N. (F) pET-30a-HvSSIIIb-N vector map, showing His6-tag (N-terminal), HvSSIIIb-N insert (41–366 aa), T7 promoter/lac operator, and kanamycin resistance marker. (G) IPTG induction of His-HvSSIIIb-N: Lanes 0–6, IPTG induction duration (hours); black arrow indicates His-HvSSIIIb-N (~40 kDa); M, 10–180 kDa protein marker; CL, total cell lysate. (H) His-HvSSIIIb-N purification profile: FT, flow-through; W1–W3, washes with non-denaturing lysis buffer; E1–E3, elutions with 250 mM imidazole; black arrow indicates purified His-HvSSIIIb-N.
Time-course analysis revealed increasing accumulation of both GST-HvSSIIIa-N (~55 kDa) and HIS-HvSSIIIb-N (~40 kDa) fusion proteins over 6 h of induction (Figure 2D,G). Following affinity purification using resins, we obtained highly pure recombinant proteins, as demonstrated by single-band detection on Coomassie-stained SDS-PAGE gels (Figure 2E,H). The purified proteins showed expected molecular weights with minimal degradation, making them suitable for subsequent antibody production.
3.3. Preparation and Characterization of Polyclonal Antibodies Against HvSSIIIa and HvSSIIIb
Quantitative analysis revealed the antibodies exhibited exceptional sensitivity, maintaining specific antigen recognition at dilutions up to 1:20,000 and detecting as little as 0.1 μg of target protein (Figure 3 and Figure 4), confirming their suitability for downstream applications. Western blot analysis of developing barley grains demonstrated dynamic expression patterns during grain maturation (5–30 days post-pollination). Quantitative assessment using ImageJ 2.0 (https://imagej.net/) software revealed significant variations in signal intensity across developmental stages (Figure 3D,E and Figure 4D,E), indicating temporal regulation of both isoforms.

Figure 3.
Specific detection of HvSSIIIa rabbit antiserum and verification of HvSSIIIa antibody in barley tissue. (A) SDS-PAGE analysis to determine the concentration of GST-HvSSIIIa-N antigen. (B) Antigen gradient-dilution Western blot method to detect the specificity of GST-HvSSIIIa-N protein expression in prokaryotic cells (antibody dilution ratio 1:400). (C) Western blot method with different antibody dilution ratios to detect the specificity of 1 μg GST-HvSSIIIa-N protein expression in prokaryotic cells. (D) Western blot method to detect the specificity of HvSSIIIa protein in barley. (E) Image J software analysis of the relative expression levels of HvSSIIIa protein at different tissue and grain developmental stages in barley. (F) Analysis of HvSSIIIa transcript levels in different tissues of barley and after different days of pollination. Data are presented as mean ± SD (n > 3). Note: total protein is 30 µg. The dilution ratio of the HvSSIIIa antibody is 1:500. Lane M: protein markers (10–180 kDa).

Figure 4.
Specific detection of HvSSIIIb rabbit antiserum and verification of HvSSIIIb antibody in barley tissue. (A) SDS-PAGE analysis was performed to determine the concentration of His-HvSSIIIb-N antigen. (B) The specificity of His-HvSSIIIb-N protein expression in prokaryotic cells was verified by antigen gradient-dilution Western blot, using an antibody dilution ratio of 1:400. (C) Western blot analysis with varying antibody dilution ratios (1:500–1:2000) confirmed the specificity of 1 μg His-HvSSIIIb-N protein expressed in prokaryotic cells. (D) The presence of HvSSIIIb protein in barley tissue was detected by Western blot. (E) Relative expression levels of HvSSIIIb protein across different barley tissues and grain developmental stages were quantified using ImageJ software. (F) Transcript levels of HvSSIIIb were analyzed in different barley tissues and at various time points after pollination. Data are presented as mean ± SD (n > 3). For all Western blot analyses, 30 μg of total protein was loaded per lane, and the HvSSIIIb antibody was used at a dilution ratio of 1:500. Protein molecular weight markers (10–180 kDa) were included in lane M, for reference.
Comprehensive tissue distribution analysis showed distinct expression patterns. HvSSIIIa exhibited grain-specific accumulation, with minimal detection in stems and leaves (Figure 3F). HvSSIIIb displayed preferential expression in photosynthetic tissues, showing highest abundance in leaves (Figure 4F). Both isoforms showed basal expression in roots, consistent with limited starch-storage capacity. Transcript-level analysis showed a consistent trend with this protein expression pattern, confirming the specificity of the antibody detection.
3.4. Functional Protein Partners of HvSSIIIa and HvSSIIIb in Barley
Immunoprecipitation experiments using our specific polyclonal antibodies successfully isolated native HvSSIIIa and HvSSIIIb protein complexes from developing barley grains. Western blot analysis of the immunoprecipitated products revealed distinct protein bands in the antibody-treated samples that were absent in control IgG precipitations (Figure 5), demonstrating the specificity of our isolation protocol. Mass spectrometric analysis of these differential bands identified several high-confidence interacting partners, including AGPase, 14-3-3 regulatory proteins, and additional starch biosynthetic enzymes (Table S2). Notably, the mass spectrometry data confirmed the specific enrichment of HvSSIIIa and HvSSIIIb in the experimental groups (≥5 unique peptides per protein, p < 0.01), while these targets were undetectable in control precipitations.

Figure 5.
Co-immunoprecipitation and Western blot analysis of HvSSIII isoforms from developing barley grains. (A) Western blot analysis of proteins immunoprecipitated from 10-day-old barley grains using anti-HvSSIIIa polyclonal antibodies. (B) Parallel immunoprecipitation and detection using anti-HvSSIIIb antibodies. Target protein bands are indicated by black arrows. Molecular weight markers (10–180 kDa, lane M) were included, for reference.
3.5. Yeast Two-Hybrid Validation of HvSSIIIb Interactions with Starch Biosynthetic Enzymes
Building upon our IP-MS results and the existing literature, we investigated potential interactions between HvSSIII isoforms and ADP-glucose pyrophosphorylase subunits (HvAGPL1 and HvAGPS1), using yeast two-hybrid analysis. The pGBKT7-HvSSIIIa-CC construct exhibited yeast toxicity, preventing colony formation even on double-dropout (-Leu/-Trp) media, while control transformations grew normally. Judging from the performance, the HvSSIIIa-CC protein expressed by this construct strongly inhibited the growth and reproduction of yeast cells, resulting in the inability of cells to form visible colonies, which indicates a relatively serious toxic effect. The possible reason lies in the fact that this coiled helical domain may have a special structure or function. After being expressed in yeast cells, it might interfere with the normal protein interaction network within yeast cells or affect the basic physiological metabolic processes of the cells, such as energy synthesis and substance transport. It could also be that this protein accumulates in large quantities within yeast cells, occupying excessive cellular resources such as amino acids and ATP, thereby inhibiting the normal growth and reproduction of yeast cells. Due to the strong toxicity of the PGBKT7-HVSIIIA-CC construct, colonies cannot form on the double-deficient medium, which makes it impossible for us to study the possible interaction between HVSIIIA-CC and the AGPase subunit, and there is a risk of false negative results. Even if there is a genuine interaction between HvSSIIIa-CC and the AGPase subunit, since yeast cells cannot grow, positive results cannot be observed through subsequent screening media. Positive controls (pGBKT7-p53/pGADT7-T) showed expected blue colony formation on quadruple-dropout (-Ade/-His/-Leu/-Trp) media with X-α-Gal, confirming system validity. Significant interaction was observed between HvSSIIIb-CC and both AGPase subunits. Co-transformation with pGADT7-HvAGPL1 produced robust growth and blue coloration on selective media. Similar interaction strength was detected with pGADT7-HvAGPS1. Negative controls grew only on double-dropout media, demonstrating interaction specificity (Figure 6).
Figure 6.
Yeast two-hybrid analysis of protein–protein interactions. Bait constructs contained the coding sequences of HvSSIIIa or HvSSIIIb, while prey constructs included ADP-glucose pyrophosphorylase subunits HvAGPL1 (XP_044984294.1) and HvAGPS1 (XP_044946641.1). Positive interactions were selected on quadruple-dropout media (SD/-Ade/-His/-Leu/-Trp) containing X-α-Gal and aureobasidin A. (Triangles are used to intuitively represent the “concentration gradient”, with the concentration gradient ranging from 10 to 10−4).
3.6. GST Pull-Down Confirms Physical Interaction Between HvSSIIIa and HvAGPL1
To biochemically validate the interaction between HvSSIIIa and ADP-glucose pyrophosphorylase large subunit (HvAGPL1), we performed GST pull-down assays using recombinant proteins. SDS-PAGE analysis confirmed successful induction and purification of GST (26 kDa), GST-HvAGPL1 (~85 kDa), and GST-CC-HvSSIIIa (~55 kDa) (Figure 7A). GST-CC-HvSSIIIa, but not GST alone, efficiently pulling down endogenous HvAGPL1 from barley grain extracts (Figure 7B). Western blot using anti-HIS-HvAGPL1 antibody specifically detected HvAGPL1 (~55 kDa) in GST-CC-HvSSIIIa precipitates, confirming the interaction. No HvAGPL1 signal was observed in GST-only controls, ruling out nonspecific binding. The interaction was retained after stringent washes (PBS + 0.1% Triton X-100), supporting a stable complex formation.

Figure 7.
The pull-down assay validation of protein interactions. (A) Western blot analysis demonstrating physical interaction between HvAGPL1 and HvSSIIIb. (B) Reciprocal interaction analysis between HvAGPL1 and HvSSIIIa. Molecular weight markers (10–180 kDa, lane M) are shown, for reference. Control experiments with empty vector proteins confirmed interaction specificity.
4. Discussion
This study successfully developed high-specificity polyclonal antibodies against barley starch synthase III isoforms (HvSSIIIa and HvSSIIIb), through an optimized prokaryotic expression and immunization protocol. The strategic selection of E. coli as an expression host provided multiple advantages, including well-characterized genetics, high transformation efficiency, and cost-effective cultivation requirements [27]. Through meticulous RT-PCR amplification, cloning, and homologous recombination, we constructed two prokaryotic expression vectors (pGEX-6p-1-HvSSIIIa-N and pET-30a-HvSSIIIb-N) that enabled high-yield production of GST-tagged recombinant proteins. The fusion tags significantly enhanced protein solubility and purification efficiency, while maintaining structural integrity, allowing for large-scale antigen production [28]. Antibody specificity was rigorously validated through Western blot analysis, demonstrating the capacity to detect endogenous HvSSIII isoforms at working dilutions up to 1:500 [11]. The dilution series experiments revealed excellent antibody titer, with consistent signal detection even at low antigen concentrations, confirming their suitability for both qualitative and quantitative applications.
Our findings substantially expand current understanding of SSIII functionality in cereal crops. Beyond its established enzymatic role in glucan chain elongation, we demonstrate that SSIII serves as a critical regulatory node in starch biosynthesis through extensive protein–protein interactions. This dual functionality aligns with emerging evidence from maize studies showing SSIII’s capacity to modulate the activity of other starch biosynthetic enzymes through physical associations. The CRISPR/Cas9-mediated knockout of SSIIIa in barley resulted in significant alterations in resistant starch content [29], strongly suggesting that these interaction networks directly influence starch quality parameters. Through comprehensive co-immunoprecipitation coupled with mass spectrometry, we took the IgG group as the control, and screened the interacting proteins of soluble starch synthase through immunoprecipitation technology. A total of 44 proteins are mainly involved in the basic processes of starch synthesis, such as the ADP-glucose pyrophosphorylase subunits (HvAGPL1 and HvAGPS1). As key rate-limiting enzymes in starch synthesis, they interact with SSIII to jointly regulate the supply of ADP-glucose precursors. Subsequently, these associations were verified through yeast two-hybrid and GST pull-down tests; the differential proteins, on the other hand, demonstrate functional differentiation. The specific proteins of SSIIIa are involved in processes such as hormone regulation (like the DELLA protein SLR1-like), while the 117 specific proteins of SSIIIb are mostly related to metabolism (such as the 14-3-3 protein), each playing a unique role in the regulatory network of starch synthesis. Among these interacting proteins, the research on AGPase is relatively abundant. Xu Guohua’s team’s study on OsAGPL1 and OsAGPS1 found that they are located in chloroplasts, catalyze the rate-limiting step of starch synthesis, and that their expression is induced by nitrogen- and phosphorus-deficiency stress [30]. The 14-3-3 protein family is involved in the regulation of various cellular processes, such as signal transduction and metabolic-enzyme activity regulation, etc. [31]. It may affect the starch synthesis process by interacting with SSIIIb, regulating the activity of enzymes related to starch synthesis or participating in the signal transduction pathways of starch synthesis. The function of the DELLA protein SLR1 has also been clarified. As a negative regulatory factor of gibberellin signal transduction, it may affect the growth and development of plants and hormone signal transduction, with indirect regulation of the expression of genes related to starch synthesis and the activity of enzymes [32]. Recent studies have also found that SUMOylation modification at specific sites can enhance the salt tolerance and yield of rice, under stress [33]. In this study, yeast two-hybrid and GST-Pulldown, as common techniques for verifying protein interactions in vitro, have certain limitations. Both rely on artificially constructed expression systems and lack the complex physiological environment in vivo, which may lead to the interactions detected in vitro not fully reflecting the real situation in vivo. However, these two methods can achieve mutual verification of results through complementary principles. Yeast two-hybrid is based on transcriptional activation to verify interaction, and GST-Pulldown is based on affinity-binding detection. The combined use of the two can reduce the possibility of false positives. Meanwhile, the Co-IP experiment adopted in this study is based on the interaction of endogenous proteins under physiological conditions, which can more truly reflect the protein binding situation under in vivo conditions. The combination of the three provides a more comprehensive chain of evidence for the verification of protein interactions.
The composition and regulation of starch biosynthetic complexes represents an area of growing research interest. While previous studies in maize and rice have identified multi-enzyme complexes containing SSIII, SBE, ISA, PUL and PHO [34], our work provides the first detailed characterization of such complexes in barley. Particularly noteworthy is our discovery of potential phosphorylation-mediated regulation of complex assembly, evidenced by the identification of 14-3-3 proteins as interaction partners. This finding suggests a sophisticated regulatory mechanism where kinase signaling pathways may directly influence starch biosynthesis through post-translational modification of SSIII isoforms. The presence of conserved 14-3-3 binding motifs in HvSSIII sequences implies an evolutionarily conserved regulatory mechanism that may modulate enzyme activity through conformational changes, similar to the well-documented phosphorylation control of AGPase [35,36]. Phosphorylation of SS can regulate its activity and interaction with other proteins involved in starch synthesis. Changes in protein activity typically require the interaction between phosphorylated proteins and adapter 14-3-3 protein. The removal or reduction of phosphate groups in immunoprecipitation and Western blot experiments, which reduces or eliminates the immunoprecipitation signal, confirms that the SSIII protein in corn binds to the 14-3-3 protein [37,38,39]. In Arabidopsis thaliana, the SSIII gene family is a potential target for the 14-3-3 protein. Studies have found that the amino acid sequence of the SSIII family contains binding domain sequences corresponding to the 14-3-3 protein, suggesting that the 14-3-3 protein may regulate starch synthesis through interaction with SSIII [38].
Several lines of evidence support the biological significance of these interactions. First, the tissue-specific expression patterns of HvSSIII isoforms correlate with known starch-accumulation profiles, suggesting functional specialization. Second, the identification of interaction domains provides mechanistic insights into complex formation. Third, the phosphorylation-dependent nature of some interactions offers potential explanations for the dynamic regulation of starch synthesis during grain development. These findings collectively advance our understanding of barley starch biosynthesis from a simple linear pathway to a sophisticated, regulated network of protein interactions and post-translational modifications.
5. Conclusions
The biosynthesis of starch in barley grains represents a sophisticated metabolic process involving coordinated action among multiple enzymatic components. Our study provides significant mechanistic insights into this process through comprehensive characterization of two key SSIII isoforms, HvSSIIIa and HvSSIIIb. We successfully established an efficient pipeline for antibody production by constructing prokaryotic expression vectors (pGEX-6p-1-HvSSIIIa-N and pET-30a-HvSSIIIb-N) and generating high-affinity rabbit polyclonal antibodies against these enzymes. These immunological tools demonstrated exceptional specificity and sensitivity in detecting endogenous HvSSIII proteins across various barley tissues, with reliable detection at dilutions up to 1:20,000. Through co-immunoprecipitation coupled with mass spectrometry, we systematically identified and validated protein interaction networks centered on HvSSIIIa and HvSSIIIb. Our findings reveal that these starch synthases form functional complexes with critical metabolic enzymes, including ADP-glucose pyrophosphorylase subunits (HvAGPL1 and HvAGPS1), suggesting a previously unrecognized mechanism for coordinating substrate supply with chain elongation. The discovery of 14-3-3 proteins as potential regulatory partners further indicates that post-translational modifications may dynamically control starch biosynthetic complex assembly and activity.
These results substantially advance our understanding of barley starch biosynthesis in three key aspects: (1) by demonstrating the scaffold function of SSIII isoforms beyond their catalytic activity, (2) by revealing isoform-specific interaction profiles that suggest functional specialization, and (3) by identifying phosphorylation as a potential regulatory switch for complex formation. The methodological framework established in this study, combining advanced protein biochemistry with immunological tools, provides a robust platform for future investigations of cereal starch biosynthesis. Overall, the findings of this study offer a new perspective for understanding the molecular mechanism of starch synthesis in barely. By targeting and regulating the interaction between SIII and key interacting proteins, the starch content and quality of crops can be optimized, providing a theoretical basis and candidate targets for breeding high-starch crops.
Supplementary Materials
The following supporting information can be downloaded at: https://www.mdpi.com/article/10.3390/agronomy15092091/s1, Table S1. Primers for yeast two-hybrid experiments. Table S2. The results of core interacting proteins of SSIIIa and SSIIIb. Table S3. The results of core interacting proteins of SSIIIa. Table S4. The results of core interacting proteins of SSIIIb. Figure S1. Protein induction map of recombinant plasmid.
Author Contributions
G.Y. and Z.F. designed the experiments. Y.G. and Q.Z. performed the experiments and analyzed the data. Z.C. helped with the construction of the expression vector. X.H., J.G. and H.T. helped with the preparation and purification of the fusion protein. L.C., Y.L. and H.Z. designed experimental ideas for antibody preparation and immunoblotting. Y.G. and Q.Z. arranged and wrote the manuscript and conferred with all authors. G.Y. read and approved the contents. All authors have read and agreed to the published version of the manuscript.
Funding
This research received no external funding.
Institutional Review Board Statement
The study was conducted in accordance with the Declaration of Helsinki, and approved by the Institutional Review Board of Sichuan Agricultural University Institutional Animal Care and Use Committee (protocol code DKY-S20230605 and date 5 June 2023).
Data Availability Statement
The original contributions presented in this study are included in the article.
Acknowledgments
We would like to express our gratitude to Lun Liu for taking time from their busy schedule to enhance the language and overall robustness of the manuscript.
Conflicts of Interest
The authors declare that the research was conducted in the absence of any commercial or financial relationship that could be construed as a potential conflict of interest.
References
- Li, R.; Zhang, R.; Yang, Y.; Li, Y. Accumulation characteristics, driving factors, and model prediction of cadmium in soil-highland barley system on the Tibetan Plateau. J. Hazard. Mater. 2023, 453, 131407. [Google Scholar] [CrossRef]
- Zhao, J.; Lancuo, Z.; Wang, W.; Wang, H.; Shen, J. Response of suitable area of highland barley in the Qinghai-Xizang Plateau to climate change based on Maximum Entropy Model analysis. Chin. J. Eco-Agric. 2024, 32, 1626–1638. [Google Scholar]
- Li, Y.; Jiang, Y.; Cao, D.; Dang, B.; Yang, X.; Fan, S.; Shen, Y.; Li, G.; Liu, B. Creating a zero amylose barley with high soluble sugar content by genome editing. Plant Mol. Biol. 2024, 114, 50. [Google Scholar] [CrossRef]
- Wang, K.; Henry, R.J.; Gilbert, R.G. Causal relations among starch biosynthesis, structure, and properties. Springer Sci. Rev. 2014, 2, 15–33. [Google Scholar] [CrossRef]
- Huang, L.; Tan, H.; Zhang, C.; Li, Q.; Liu, Q. Starch biosynthesis in cereal endosperms: An updated review over the last decade. Plant Commun. 2021, 2, 100237. [Google Scholar] [CrossRef]
- Cuesta-Seijo, J.A.; Nielsen, M.M.; Ruzanski, C.; Krucewicz, K.; Beeren, S.R.; Rydhal, M.G.; Yoshimura, Y.; Striebeck, A.; Motawia, M.S.; Willats, W.G.; et al. In vitro biochemical characterization of all barley endosperm starch synthases. Front. Plant Sci. 2016, 6, 1265. [Google Scholar] [CrossRef]
- Sharma, V.; Jahan, K.; Kumar, P.; Puri, A.; Sharma, V.K.; Mishra, A.; Bharatam, P.V.; Sharma, D.; Rishi, V.; Roy, J. Mechanistic insights into granule-bound starch synthase I (GBSSI.L539P) allele in high amylose starch biosynthesis in wheat (Triticum aestivum L.). Funct. Integr. Genom. 2022, 23, 20. [Google Scholar] [CrossRef] [PubMed]
- Asare, E.K.; Båga, M.; Rossnagel, B.G.; Chibbar, R.N. Polymorphism in the barley granule bound starch synthase 1 (Gbss1) gene associated with grain starch variant amylose concentration. J. Agric. Food Chem. 2012, 60, 10082–10092. [Google Scholar] [CrossRef] [PubMed]
- Yu, G.; Gaoyang, Y.; Liu, L.; Shoaib, N.; Deng, Y.; Zhang, N.; Li, Y.; Huang, Y. The structure, function, and regulation of starch synthesis enzymes SSIII with emphasis on maize. Agronomy 2022, 12, 1359. [Google Scholar] [CrossRef]
- Zhong, Y.; Bertoft, E.; Li, Z.; Blennow, A.; Liu, X. Amylopectin starch granule lamellar structure as deduced from unit chain length data. Food Hydrocoll. 2020, 108, 106053. [Google Scholar] [CrossRef]
- Radchuk, V.V.; Borisjuk, L.; Sreenivasulu, N.; Merx, K.; Mock, H.P.; Rolletschek, H.; Wobus, U.; Weschke, W. Spatiotemporal profiling of starch biosynthesis and degradation in the developing barley grain. Plant Physiol. 2009, 150, 190–204. [Google Scholar] [CrossRef] [PubMed]
- Bertoft, E.; Koch, K.; Åman, P. Building block organisation of clusters in amylopectin from different structural types. Int. J. Biol. Macromol. 2012, 50, 1212–1223. [Google Scholar] [CrossRef] [PubMed]
- Yang, H.; Dong, X.; Chai, Y.; Cui, S.; Tian, L.; Zhang, J.; Qu, L.Q. Loss-of-function of SSIIa and SSIIIa confers high resistant starch content in rice endosperm. Carbohydr. Polym. 2025, 348, 122871. [Google Scholar] [CrossRef] [PubMed]
- Ying, Y.; Hu, Y.; Zhang, Y.; Tappiban, P.; Zhang, Z.; Dai, G.; Deng, G.; Bao, J.; Xu, F. Identification of a new allele of soluble starch synthase IIIa involved in the elongation of amylopectin long chains in a chalky rice mutant. Plant Sci. 2023, 328, 111567. [Google Scholar] [CrossRef]
- Li, Z.; Li, D.; Du, X.; Wang, H.; Larroque, O.; Jenkins, C.L.; Jobling, S.A.; Morell, M.K. The barley amo1 locus is tightly linked to the starch synthase IIIa gene and negatively regulates expression of granule-bound starch synthetic genes. J. Exp. Bot. 2011, 62, 5217–5231. [Google Scholar] [CrossRef]
- Borén, M.; Glaring, M.A.; Ghebremedhin, H.; Olsson, H.; Blennow, A.; Jansson, C. Molecular and physicochemical characterization of the high-amylose barley mutant Amo1. J. Cereal Sci. 2008, 47, 79–89. [Google Scholar] [CrossRef]
- Smith, A.M.; Zeeman, S.C. Starch: A flexible, adaptable carbon store coupled to plant growth. Annu. Rev. Plant Biol. 2020, 71, 217–245. [Google Scholar] [CrossRef]
- Cao, H.; Imparl-Radosevich, J.; Guan, H.; Keeling, P.L.; James, M.G.; Myers, A.M. Identification of the soluble starch synthase activities of maize endosperm. Plant Physiol. 1999, 120, 205–215. [Google Scholar] [CrossRef]
- Fujita, N.; Yoshida, M.; Asakura, N.; Ohdan, T.; Miyao, A.; Hirochika, H.; Nakamura, Y. Function and characterization of starch synthase I using mutants in rice. Plant Physiol. 2006, 140, 1070–1084. [Google Scholar] [CrossRef] [PubMed]
- Yan, H.; Zhang, W.; Wang, Y.; Jin, J.; Xu, H.; Fu, Y.; Shan, Z.; Wang, X.; Teng, X.; Li, X.; et al. Rice LIKE EARLY STARVATION1 cooperates with FLOURY ENDOSPERM6 to modulate starch biosynthesis and endosperm development. Plant Cell 2024, 36, 1892–1912. [Google Scholar] [CrossRef]
- Hennen-Bierwagen, T.A.; Liu, F.; Marsh, R.S.; Kim, S.; Gan, Q.; Tetlow, I.J.; Emes, M.J.; James, M.G.; Myers, A.M. Starch biosynthetic enzymes from developing maize endosperm associate in multisubunit complexes. Plant Physiol. 2008, 146, 1892–1908. [Google Scholar] [CrossRef]
- Liu, F.; Romanova, N.; Lee, E.A.; Ahmed, R.; Evans, M.; Gilbert, E.P.; Morell, M.K.; Emes, M.J.; Tetlow, I.J. Glucan affinity of starch synthase IIa determines binding of starch synthase I and starch-branching enzyme IIb to starch granules. Biochem. J. 2012, 448, 373–387. [Google Scholar] [CrossRef]
- Xu, X.; Dees, D.; Dechesne, A.; Huang, X.F.; Visser, R.G.F.; Trindade, L.M. Starch phosphorylation plays an important role in starch biosynthesis. Carbohydr. Polym. 2017, 157, 1628–1637. [Google Scholar] [CrossRef]
- Crofts, N.; Abe, N.; Oitome, N.F.; Matsushima, R.; Hayashi, M.; Tetlow, I.J.; Emes, M.J.; Nakamura, Y.; Fujita, N. Amylopectin biosynthetic enzymes from developing rice seed form enzymatically active protein complexes. J. Exp. Bot. 2015, 66, 4469–4482. [Google Scholar] [CrossRef] [PubMed]
- Hennen-Bierwagen, T.A.; Lin, Q.; Grimaud, F.; Planchot, V.; Keeling, P.L.; James, M.G.; Myers, A.M. Proteins from multiple metabolic pathways associate with starch biosynthetic enzymes in high molecular weight complexes: A model for regulation of carbon allocation in maize amyloplasts. Plant Physiol. 2009, 149, 1541–1559. [Google Scholar] [CrossRef]
- Mehrpouyan, S.; Menon, U.; Tetlow, I.J.; Emes, M.J. Protein phosphorylation regulates maize endosperm starch synthase IIa activity and protein−protein interactions. Plant J. 2021, 105, 1098–1112. [Google Scholar] [CrossRef]
- Chen, G.; Zhu, J.; Zhou, L.; Subburaj, S.; Zhang, M.; Han, C.; Hao, P.; Li, X.; Yan, Y. Dynamic development of starch granules and the regulation of starch biosynthesis in Brachypodium distachyon: Comparison with common wheat and Aegilops peregrina. BMC Plant Biol. 2014, 14, 198. [Google Scholar] [CrossRef]
- Liu, L.; Qing, Y.; Shoaib, N.; Di, R.; Liu, H.; Li, Y.; Hu, Y.; Huang, Y.; Yu, G. Preparation of Polyclonal Antibody against ZmBT1 Protein and Its Application in Hormone-Regulated Starch Synthesis. Agronomy 2023, 13, 1805. [Google Scholar] [CrossRef]
- Yang, Q.; Ral, J.P.; Wei, Y.; Zheng, Y.; Li, Z.; Jiang, Q. Genome editing of five starch synthesis genes produces highly resistant starch and dietary fibre in barley grains. Plant Biotechnol. J. 2024, 22, 2051–2053. [Google Scholar] [CrossRef]
- Meng, Q.; Zhang, W.; Hu, X.; Shi, X.; Chen, L.; Dai, X.; Qu, H.; Xia, Y.; Liu, W.; Gu, M.; et al. Two ADP-glucose pyrophosphorylase subunits, OsAGPL1 and OsAGPS1, modulate phosphorus homeostasis in rice. Plant J. 2020, 104, 1269–1284. [Google Scholar] [CrossRef] [PubMed]
- Ying, C.Y.; Jie, W.D.; Yuan, L.; Hang, Z.; Jiao, L.Y.; Yu, W.J.; Ruili, L. Research progress on 14-3-3 proteins and Their Functions in plants. Biotechnol. Bull. 2024, 40, 12–22. [Google Scholar]
- Xue, H.; Gao, X.; He, P.; Xiao, G. Origin, evolution, and molecular function of DELLA proteins in plants. Crop J. 2022, 10, 287–299. [Google Scholar] [CrossRef]
- Fernandes, T.; Gonçalves, N.M.; Matiolli, C.C.; Rodrigues, M.A.A.; Barros, P.M.; Oliveira, M.M.; Abreu, I.A. SUMOylation of rice DELLA SLR1 modulates transcriptional responses and improves yield under salt stress. Planta 2024, 260, 136. [Google Scholar] [CrossRef]
- Liu, W.; Zhang, B.; He, W.; Wang, Z.; Li, G.; Liu, J. Characterization of in vivo phosphorylation modification of differentially accumulated proteins in cotton fiber-initiation process. Acta Biochim. Biophys. Sin. 2016, 48, 756–761. [Google Scholar] [CrossRef]
- Walley, J.W.; Shen, Z.; Sartor, R.; Wu, K.J.; Osborn, J.; Smith, L.G.; Briggs, S.P. Reconstruction of protein networks from an atlas of maize seed proteotypes. Proc. Natl. Acad. Sci. USA 2013, 110, e4808–e4817. [Google Scholar] [CrossRef] [PubMed]
- Carpenter, M.A.; Joyce, N.I.; Genet, R.A.; Cooper, R.D.; Murray, S.R.; Noble, A.D.; Butler, R.C.; Timmerman-Vaughan, G.M. Starch phosphorylation in potato tubers is influenced by allelic variation in the genes encoding glucan water dikinase, starch branching enzymes I and II, and starch synthase III. Front. Plant Sci. 2015, 6, 143. [Google Scholar] [CrossRef] [PubMed]
- Sehnke, P.C.; Chung, H.J.; Wu, K.; Ferl, R.J. Regulation of starch accumulation by granule-associated plant 14-3-3 proteins. Proc. Natl. Acad. Sci. USA 2001, 98, 765–770. [Google Scholar] [CrossRef]
- Diaz, C.; Kusano, M.; Sulpice, R.; Araki, M.; Redestig, H.; Saito, K.; Stitt, M.; Shin, R. Determining novel functions of Arabidopsis14-3-3 proteins in central metabolic processes. BMC Syst. Biol. 2011, 5, 192. [Google Scholar] [CrossRef]
- Comparot, S.; Lingiah, G.; Martin, T. Function and specificity of 14-3-3 proteins in the regulation of carbohydrate and nitrogen metabolism. J. Exp. Bot. 2003, 54, 595–604. [Google Scholar] [CrossRef] [PubMed]
Disclaimer/Publisher’s Note: The statements, opinions and data contained in all publications are solely those of the individual author(s) and contributor(s) and not of MDPI and/or the editor(s). MDPI and/or the editor(s) disclaim responsibility for any injury to people or property resulting from any ideas, methods, instructions or products referred to in the content. |
© 2025 by the authors. Licensee MDPI, Basel, Switzerland. This article is an open access article distributed under the terms and conditions of the Creative Commons Attribution (CC BY) license (https://creativecommons.org/licenses/by/4.0/).







